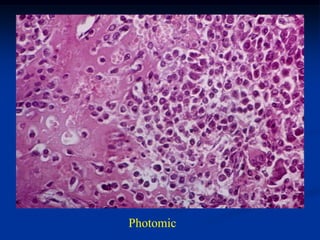
Photomic
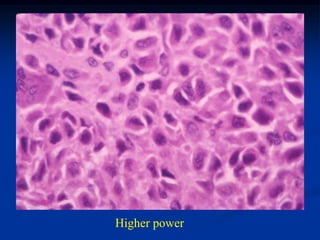
Higher power
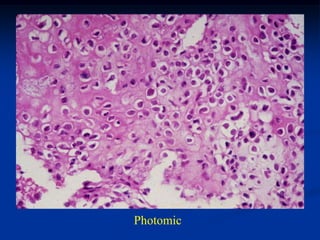
Photomic
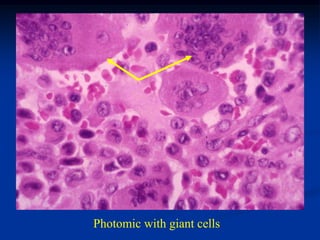
Photomic with giant cells
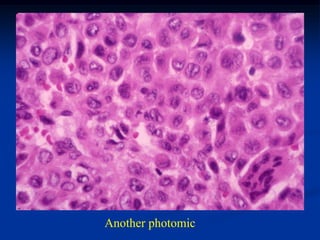
Another photomic

The document discusses several benign chondroid tumors including enchondroma, multiple enchondromatosis (Ollier's disease), Maffucci's syndrome, and periosteal chondroma. Enchondromas are common benign bone tumors that frequently occur in the hands and feet. Multiple enchondromatosis is a rare condition where multiple enchondromas form, often on one side of the body. Maffucci's syndrome involves multiple enchondromas along with soft tissue hemangiomas. Periosteal chondromas are similar to enchondromas but form on the surface of bones rather than internally.